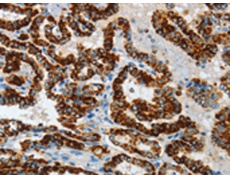
一抗

中文名稱:兔抗ASB4多克隆抗體
|
Background: |
The protein encoded by this gene is a member of the ankyrin repeat and SOCS box-containing (ASB) family of proteins. They contain ankyrin repeat sequence and SOCS box domain. The SOCS box serves to couple suppressor of cytokine signalling (SOCS) proteins and their binding partners with the elongin B and C complex, possibly targeting them for degradation. Multiple alternatively spliced transcript variants have been described for this gene but some of the full length sequences are not known. |
|
Applications: |
ELISA, IHC |
|
Name of antibody: |
ASB4 |
|
Immunogen: |
Fusion protein of human ASB4 |
|
Full name: |
ankyrin repeat and SOCS box containing 4 |
|
Synonyms: |
ASB-4 |
|
SwissProt: |
Q9Y574 |
|
ELISA Recommended dilution: |
1000-5000 |
|
IHC positive control: |
Human thyroid cancer |
|
IHC Recommend dilution: |
50-200 |

 購物車
購物車 幫助
幫助
 021-54845833/15800441009
021-54845833/15800441009